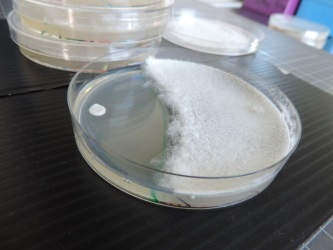

L’émergence de solutions innovantes de protection (produits de biocontrôle, stimulateurs des défenses des plantes…) permet d’envisager une gestion durable des cultures face aux maladies. Nous disposons d’outils et de compétences en phytopathologie permettant d’évaluer l’efficacité de vos produits sur différentes maladies (foliaires ou telluriques, bactériennes ou fongiques) et d’en appréhender le mode d’action.
Un produit de protection peut avoir un niveau d’efficacité variable en fonction de la maladie concernée et des conditions d’utilisation. Vegenov dispose d’équipements permettant d’évaluer l’efficacité de vos produits en conditions contrôlées sur près de 30 maladies (foliaires ou telluriques, bactériennes ou fongiques) sur un total d’une vingtaine d’espèces de plantes (grandes cultures, cultures légumières, ornementales…). Nous développons également de nouveaux pathotests sur demande .

Evaluation de l’efficacité de protection de produits de biocontrôle vis-à-vis de l’oïdium de la tomate

Application de produits de traitements en conditions contrôlées
Nous avons développé des protocoles standardisés qui nous permettent de contrôler l’infection du pathogène et d’évaluer le développement des symptômes selon une échelle de notation précise. Nous pouvons ainsi vous aider à mieux connaitre votre produit et en optimiser l’efficacité, en en déterminant par exemple la dose, la formulation ou le positionnement optimal sur différentes maladies.
Nous disposons de 11 compartiments de serre et 9 chambres de culture qui peuvent être régulés indépendamment pour la température, l’hygrométrie et la luminosité. Nous pouvons ainsi évaluer l’efficacité de vos produits selon différents paramètres.
La compréhension du mode d’action d’un produit de protection des plantes est importante pour pouvoir mieux le positionner et le valoriser.
Nous disposons d’équipements de biochimie, de biologie moléculaire, de phénotypage in vitro et in planta macro et microscopiques nous permettant d’appréhender le mode d’action des produits de protection des plantes.

Evaluation de l’impact des produits de biocontrôle et de protection sur l’expression des gènes de défense de la plante

Détection de la présence de lignine sur des coupes transversales de blé
Nous pouvons notamment déterminer l’induction des défenses des plantes par des approches transcriptomiques, puce qPFD® (Licence INRAE).
Nous pouvons également évaluer l’effet direct de votre produit sur un pathogène donné : fongique, bactérien. Nous pouvons par exemple déterminer l’inhibition de la germination de spores fongiques, de la croissance mycélienne ou de la multiplication bactérienne.
Evaluation de l’effet direct de produit de protection vis à vis de Sclerotium cepivorum

Découvrez nos savoir-faire en vidéo
